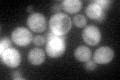
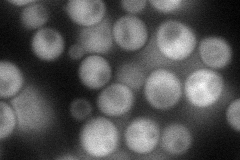
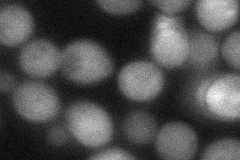
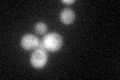

View description
One of two S. cerevisiae homologs (Sds23p and Sds24p) of the S. pombe Sds23 protein, which is implicated in APC/cyclosome regulation; involved in cell separation during budding
Localization:
Intensity:
Fold change:
Significance:
-
C’ GFP library in SD
cytosol70.04 -
N' NOP1pr-GFP in SD
cytosol78.5639 -
N' TEF2pr-mCherry in SD

cytosol101.021 -
N' NATIVEpr-GFP in SD

cytosol47.2713 -
N' TEF2pr-VC and Cyto-VN in SD
cytosol56.5949 -
C’ GFP library in SD+DTT

cytosol700.99No -
C’ GFP library in SD+H2O2
cytosol67.350.96No -
C’ GFP library in Starvation Media

cytosol55.540.79No -
C’ GFP library on the background of Pup2-DaMP

cytosol -
C’ GFP library on the background of CCT mutant

cytosol64.21750.916854No
